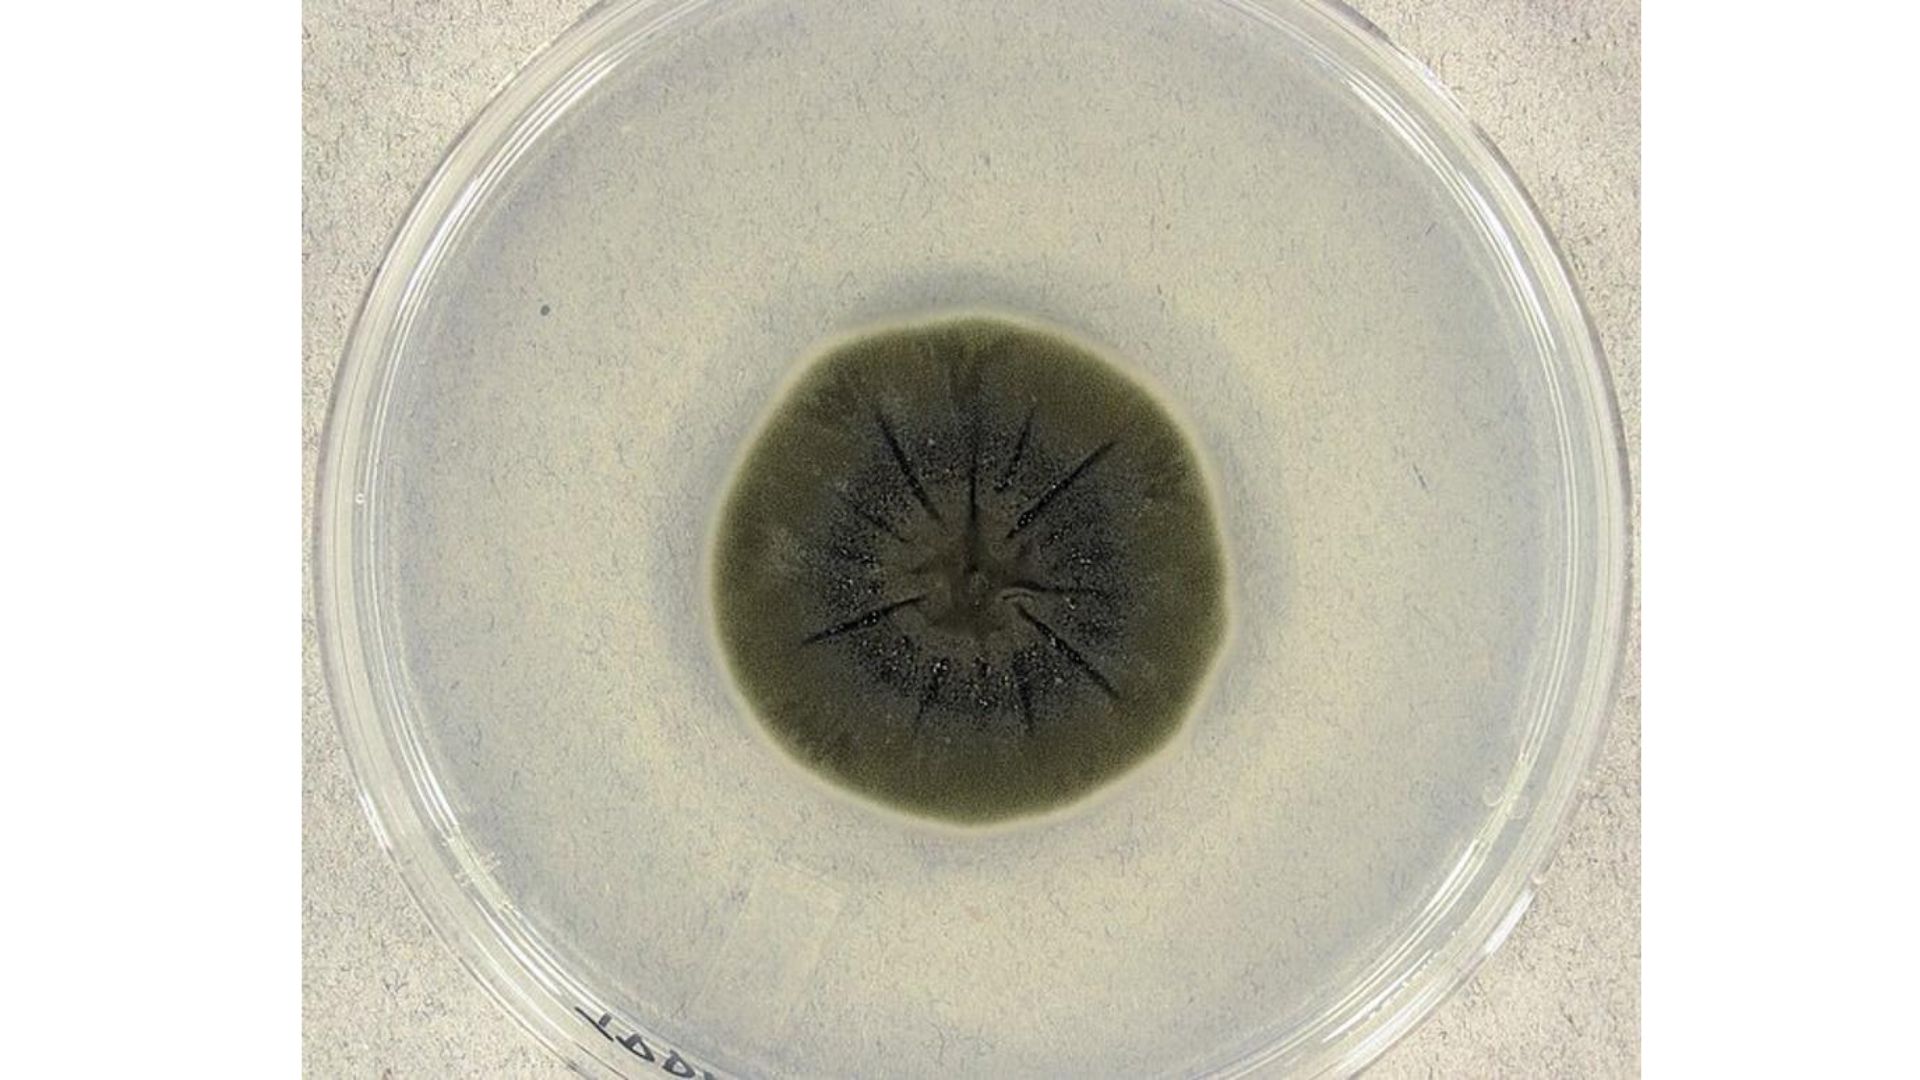
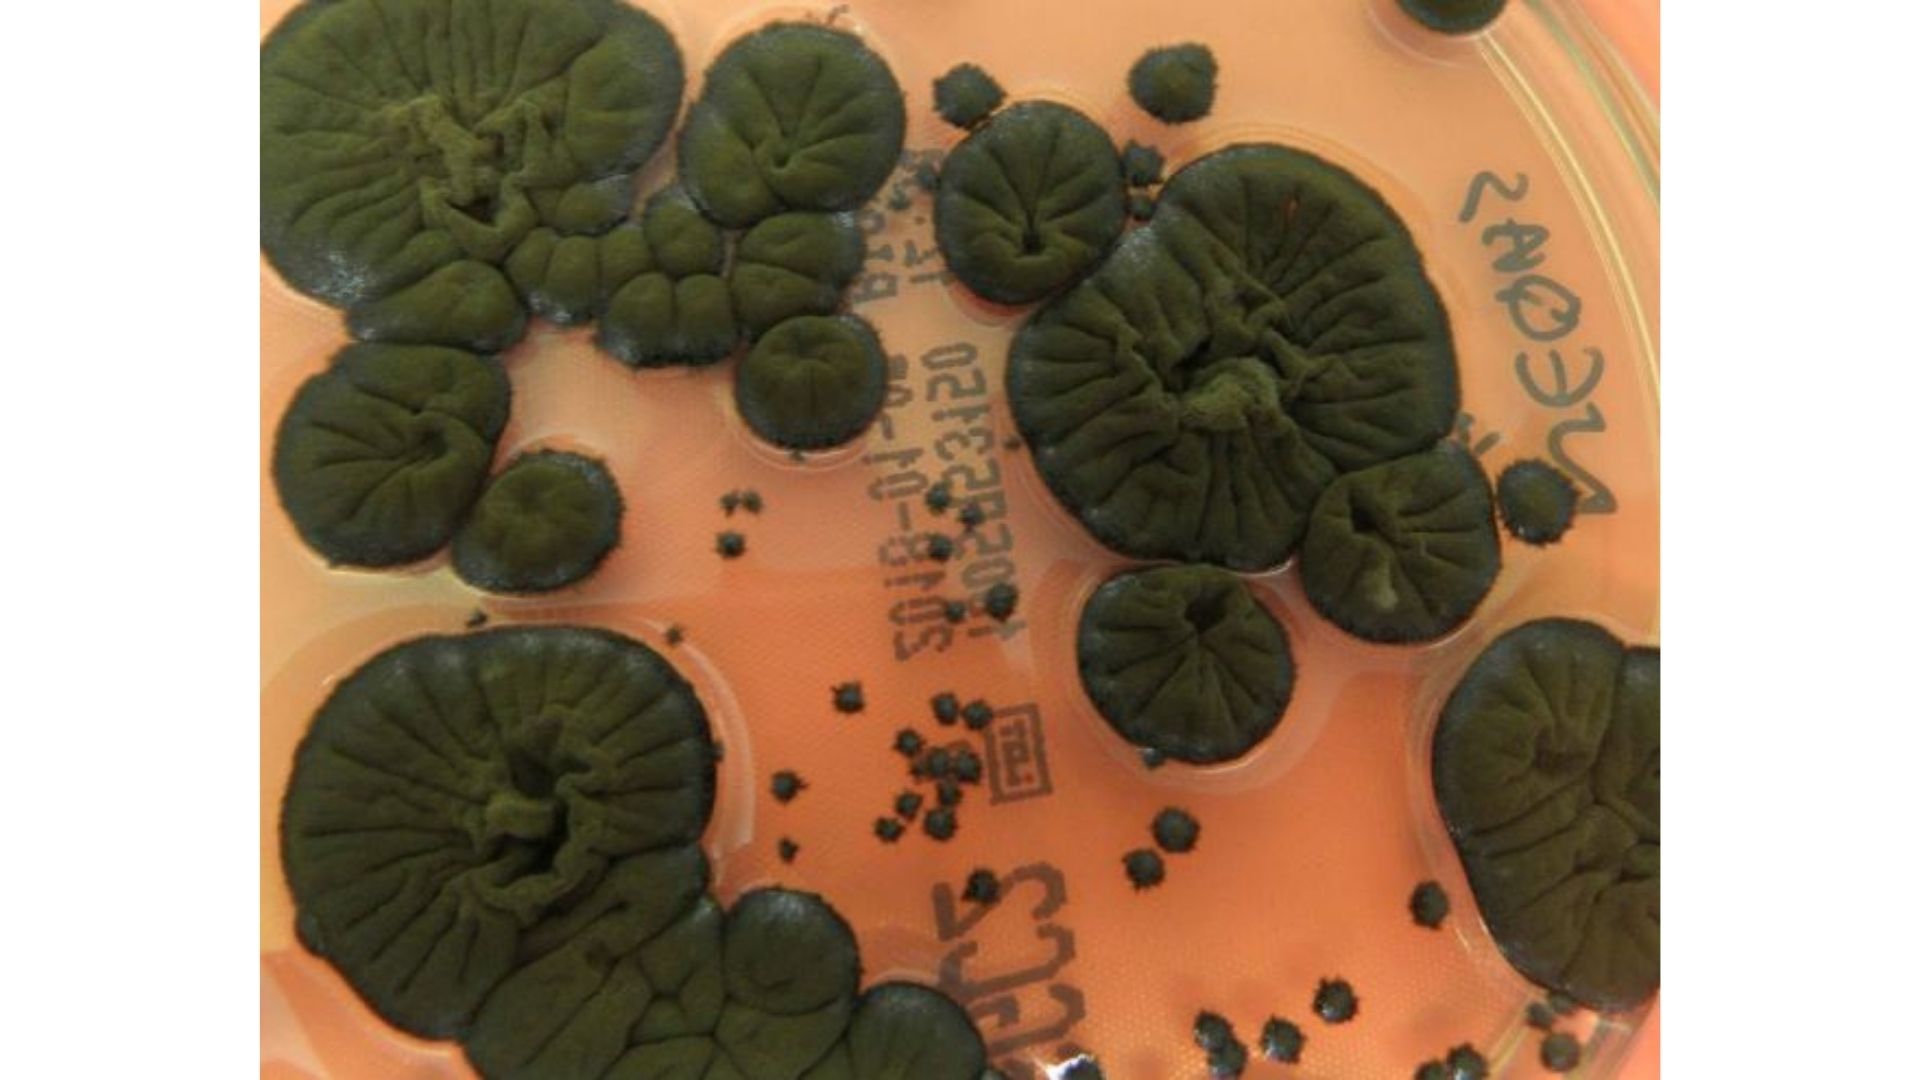

วิดิโอไลฟ์สด
https://www.youtube.com/watch?v=UjISR62hTVE
วิดิโอพิธีมอบรางวัลอิกโนเบลปี 2021
https://vimeo.com/599769861
BIOLOGY PRIZE [SWEDEN]:
Susanne Schötz, Robert Eklund, and Joost van de Weijer, for analyzing variations in purring, chirping, chattering, trilling, tweedling, murmuring, meowing, moaning, squeaking, hissing, yowling, howling, growling, and other modes of cat–human communication.
REFERENCE: “A Comparative Acoustic Analysis of Purring in Four Cats,” Susanne Schötz and Robert Eklund, Proceedings of Fonetik 2011, Speech, Music and Hearing, KTH, Stockholm, TMH-QPSR, 51.
REFERENCE: “A Phonetic Pilot Study of Vocalisations in Three Cats,” Susanne Schötz, Proceedings of Fonetik 2012, Department of Philosophy, Linguistics and Theory of Science, University of Gothenburg, Sweden.
REFERENCE: “A Phonetic Pilot Study of Chirp, Chatter, Tweet and Tweedle in Three Domestic Cats,” Susanne Schötz, Proceedings of Fonetik 2013, Linköping University, Sweden, 2013, pp. 65-68.
REFERENCE: “A Study of Human Perception of Intonation in Domestic Cat Meows,” Susanne Schötz and Joost van de Weijer, Proceedings of the 7th International Conference on Speech Prosody, Dubin, Ireland, May 20-23, 2014.
REFERENCE: “Melody in Human–Cat Communication (Meowsic): Origins, Past, Present and Future,” Susanne Schötz, Robert Eklund, and Joost van de Weijer, 2016.
WHO TOOK PART IN THE CEREMONY: Susanne Schötz
https://www.youtube.com/watch?v=wkRcwGdaeSE
https://www.youtube.com/watch?v=bvS2SlJuLp8
ECOLOGY PRIZE [SPAIN. IRAN]:
Leila Satari, Alba Guillén, Àngela Vidal-Verdú, and Manuel Porcar, for using genetic analysis to identify the different species of bacteria that reside in wads of discarded chewing gum stuck on pavements in various countries.
REFERENCE: “The Wasted Chewing Gum Bacteriome,” Leila Satari, Alba Guillén, Àngela Vidal-Verdú, and Manuel Porcar, Scientific Reports, vol. 10, no. 16846, 2020.
WHO TOOK PART IN THE CEREMONY: Leila Satari, Alba Guillén, Àngela Vidal-Verdú, Manuel Porcar
CHEMISTRY PRIZE [GERMANY, UK, NEW ZEALAND, GREECE, CYPRUS, AUSTRIA]:
Jörg Wicker, Nicolas Krauter, Bettina Derstroff, Christof Stönner, Efstratios Bourtsoukidis, Achim Edtbauer, Jochen Wulf, Thomas Klüpfel, Stefan Kramer, and Jonathan Williams, for chemically analyzing the air inside movie theaters, to test whether the odors produced by an audience reliably indicate the levels of violence, sex, antisocial behavior, drug use, and bad language in the movie the audience is watching.
REFERENCE: “Proof of Concept Study: Testing Human Volatile Organic Compounds as Tools for Age Classification of Films,” Christof Stönner, Achim Edtbauer, Bettina Derstroff, Efstratios Bourtsoukidis, Thomas Klüpfel, Jörg Wicker, and Jonathan Williams, PLoS ONE, vol. 13, no. 10, 2008, p. e0203044.
REFERENCE: “Cinema Data Mining: The Smell of Fear,” Jörg Wicker, Nicolas Krauter, Bettina Derstorff, Christof Stönner, Efstratios Bourtsoukidis, Thomas Klüpfel, Jonathan Williams, and Stefan Kramer, Proceedings of the 21th ACM SIGKDD International Conference on Knowledge Discovery and Data Mining, pp. 1295-1304. 2015.
WHO TOOK PART IN THE CEREMONY: Jörg Wicker, Nicolas Krauter, Bettina Derstroff, Christof Stönner, Efstratios Bourtsoukidis, Achim Edtbauer, Jochen Wulf, Thomas Klüpfel, Stefan Kramer, Jonathan Williams
ECONOMICS PRIZE [FRANCE, SWITZERLAND, AUSTRALIA, AUSTRIA, CZECH REPUBLIC, UK]:
Pavlo Blavatskyy, for discovering that the obesity of a country’s politicians may be a good indicator of that country’s corruption.
REFERENCE: “Obesity of Politicians and Corruption in Post‐Soviet Countries,” Pavlo Blavatskyy, Economic of Transition and Institutional Change, vol. 29, no. 2, 2021, pp. 343-356.
WHO TOOK PART IN THE CEREMONY: Pavlo Blavatskyy
ตัวอย่างโปรแกรมที่ไว้คำนวณ BMI จากภาพถ่ายใบหน้า เผื่อใครอยากลองไปเล่นดู
https://medium.

 Our TOPPODCAST Picks
Our TOPPODCAST Picks  Stay Connected
Stay Connected

เชิญชวนชาวเบร้อทุกท่านมาปฏิบัติกรรม
กับงานแฟนมีตที่เบร้อที่สุดในจักรวาล
.
เปิดรูจมูกให้บาน แล้วมาร่วมสูดดดดดกันให้เต็มปอด
ใน (มินิ) แฟนมีตครั้งที่ 1 ของชาว WiTcast
.
ครั้งแรกที่เราจะได้เจอกันเป็น ๆ แบบใกล้ชิดสุด ๆ
เชิญชวนชาวเบร้อทุกท่านมาปฏิบัติกรรม
กับงานแฟนมีตที่เบร้อที่สุดในจักรวาล
.
เปิดรูจมูกให้บาน แล้วมาร่วมสูดดดดดกันให้เต็มปอด
ใน (มินิ) แฟนมีตครั้งที่ 1 ของชาว WiTcast
.
ครั้งแรกที่เราจะได้เจอกันเป็น ๆ แบบใกล้ชิดสุด ๆ
 พบกันวันที่ 20 และ 21 กันยายน 2568 (2 รอบ)
เวลา 13:00 – 18:00 น.
ที่ Somerset Ekamai Bangkok
พบกันวันที่ 20 และ 21 กันยายน 2568 (2 รอบ)
เวลา 13:00 – 18:00 น.
ที่ Somerset Ekamai Bangkok








 ดูเวอร์ชั่นละเอียดยิบได้ทาง
ดูเวอร์ชั่นละเอียดยิบได้ทาง


 ของหมูมิ้นที่เล่ามิวเซียม Science Museum ของสิงคโปร์ กับ MoMath ที่นิวยอร์ก โหลดไฟล์นี้ไปดูรูปประกอบกันได้
ของหมูมิ้นที่เล่ามิวเซียม Science Museum ของสิงคโปร์ กับ MoMath ที่นิวยอร์ก โหลดไฟล์นี้ไปดูรูปประกอบกันได้






































































































































































 ช่วงที่ 1 “ผลกระทบจากความรุนแรงด้วยเหตุแห่งเพศ: การป้องกันและช่วยเหลือ”
ผู้เข้าร่วมได้เรียนรู้จากประสบการณ์ของคุณอังคนา อินทสา มูลนิธิหญิงชายก้าวไกล, ดร.วราภรณ์ แช่มสนิท ที่ปรึกษาแผนงานสุขภาวะผู้หญิงและความเป็นธรรมทางเพศ และ นพ.พงศกร เล็งดี ผู้อำนวยการศูนย์สุขภาพจิตที่ 13 กรมสุขภาพจิต ที่ได้ช่วยเปิดมุมมองถึงผลกระทบที่เกิดจากความรุนแรงที่ส่งผลเสียอย่างลึกซึ้งต่อทุกด้านของชีวิต การป้องกันและแก้ไขปัญหาเหล่านี้ต้องอาศัยความร่วมมือจากทุกภาคส่วนในสังคม ตั้งแต่การสร้างความตระหนักรู้ การเปลี่ยนแปลงทัศนคติ ไปจนถึงการจัดการช่วยเหลือที่มีประสิทธิภาพและยั่งยืน
ช่วงที่ 1 “ผลกระทบจากความรุนแรงด้วยเหตุแห่งเพศ: การป้องกันและช่วยเหลือ”
ผู้เข้าร่วมได้เรียนรู้จากประสบการณ์ของคุณอังคนา อินทสา มูลนิธิหญิงชายก้าวไกล, ดร.วราภรณ์ แช่มสนิท ที่ปรึกษาแผนงานสุขภาวะผู้หญิงและความเป็นธรรมทางเพศ และ นพ.พงศกร เล็งดี ผู้อำนวยการศูนย์สุขภาพจิตที่ 13 กรมสุขภาพจิต ที่ได้ช่วยเปิดมุมมองถึงผลกระทบที่เกิดจากความรุนแรงที่ส่งผลเสียอย่างลึกซึ้งต่อทุกด้านของชีวิต การป้องกันและแก้ไขปัญหาเหล่านี้ต้องอาศัยความร่วมมือจากทุกภาคส่วนในสังคม ตั้งแต่การสร้างความตระหนักรู้ การเปลี่ยนแปลงทัศนคติ ไปจนถึงการจัดการช่วยเหลือที่มีประสิทธิภาพและยั่งยืน
































































 ข่าวเฝ้าระวังไวรัสไข้หวัดนก H5N1 ในนมวัวที่อเมริกา
ข่าวเฝ้าระวังไวรัสไข้หวัดนก H5N1 ในนมวัวที่อเมริกา
 เรื่องราววิวัฒนาการใน DNA ของตุ่น Marsupial
เรื่องราววิวัฒนาการใน DNA ของตุ่น Marsupial


 ข่าวอวกาศ ส่งยาน Starship และ New Glenn
ข่าวอวกาศ ส่งยาน Starship และ New Glenn


















































































































































































































































































 https://www.youtube.com/watch?v=YmjD9bQck0Q
– รัสเซีย vs อินเดีย แข่งลงดวงจันทร์ –
https://www.youtube.com/watch?v=YmjD9bQck0Q
– รัสเซีย vs อินเดีย แข่งลงดวงจันทร์ –



 https://www.youtube.com/watch?v=DLA_64yz8Ss
Virgin Galactic เที่ยวบินอวกาศ ไฟลท์ที่ 2 –
https://www.youtube.com/watch?v=DLA_64yz8Ss
Virgin Galactic เที่ยวบินอวกาศ ไฟลท์ที่ 2 – 
 ไฟไหม้ครั้งใหญ่ที่เมาวี –
ไฟไหม้ครั้งใหญ่ที่เมาวี –
 – gene therapy ทำหมันแมวแบบเข็มเดียวจบ –
– gene therapy ทำหมันแมวแบบเข็มเดียวจบ –
 Sponsor หอแว่น แจกโปรลด 25%
https://www.youtube.com/watch?v=Hua7QWeVUR4
– ระบบนิเวศใหม่ เขาวงกตใต้ปล่อง hydrothermal vents –
Sponsor หอแว่น แจกโปรลด 25%
https://www.youtube.com/watch?v=Hua7QWeVUR4
– ระบบนิเวศใหม่ เขาวงกตใต้ปล่อง hydrothermal vents –





 https://www.youtube.com/watch?v=neyccYHaAGo
– วิเคราะห์ reaction time ของระบบประสาทมนุษย์และสัตว์ต่างๆ เทียบกับการระบุบ (implosion) ของเรือดำน้ำไททัน
https://www.facebook.com/watch/?v=805121701207568
https://www.youtube.com/watch?v=neyccYHaAGo
– วิเคราะห์ reaction time ของระบบประสาทมนุษย์และสัตว์ต่างๆ เทียบกับการระบุบ (implosion) ของเรือดำน้ำไททัน
https://www.facebook.com/watch/?v=805121701207568

 – ปลาปากแตรหลบหลังปลานกแก้ว –
– ปลาปากแตรหลบหลังปลานกแก้ว – 


 – Long Covid / Brain Fog เกิดจากเซลล์ประสาท fuse กัน –
– Long Covid / Brain Fog เกิดจากเซลล์ประสาท fuse กัน – 








